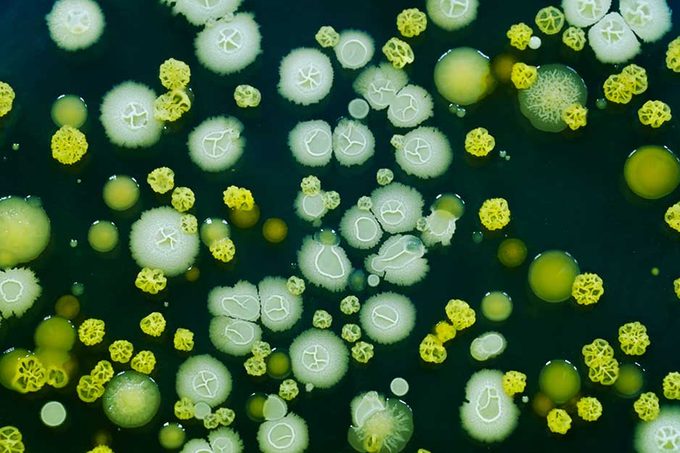
bacteria

Your mom was right—handwashing can prevent the common cold, diarrhea, and even serious diseases.
Here’s Why You Really Need to Wash Your Hands
Parents and preschool teachers drill the importance of handwashing into kids from the moment they’re old enough to climb up on that bathroom stool and reach the faucet. And they’re right to do so: Science proves that handwashing is a quick and easy way to fight off germs and infections.
One of the most important places for regular handwashing is a healthcare setting, but it also makes a difference in other places too. Providing soap and educating people about handwashing can reduce diarrhea episodes by 30 percent in schools and daycare centers, according to a 2015 analysis of studies published in the Cochrane Review. Most of us would do just about anything to avoid unpleasant illnesses, so a simple trip to the bathroom sink is definitely worth it—especially when you consider that diarrhea is just one of the 7 things that can happen when you don’t wash your hands. Here are some of the ways that handwashing protects you.
First, the good news: Most germs won’t make you sick
Luckily, if you have a healthy immune system, your body is already fighting off most germs that come your way. “In our world, there are billions of germs,” says immunologist Lina Velikova, MD. “Most of them are harmless because our immune system has evolved to protect us against them.”
Some germs like the healthy bacteria in our guts are good for us. However, there are plenty of other bugs that can lead to serious infections. Check out these 9 ways to protect yourself against the next viral outbreak.
Germ exposure is constant
Your body is being exposed to germs all day long, from your first bathroom trip in the morning all the way to cleaning up dinner dishes at the end of the night. Each day you’re exposed to viruses, bacteria, fungi, and parasites.
So which germs are more likely to make you sick? “Well, that somewhat depends on the time of year, where you live, and whom you hang out with,” says David Cutler, MD, family medicine physician at Providence Saint John’s Health Center in Santa Monica, California.
It can also depend on how your immune system is functioning and whether you have been vaccinated against a specific virus (like influenza) or exposed to the germ in the past. (Sometimes past exposure means you won’t get ill or as sick the second time, while other germs—like some that cause food poisoning—can make you sick every time you come into contact with them.)
Be vigilant about handwashing, especially during the winter months
There’s a reason why half of your child’s class is home sick from school every winter. During those colder months, cold and flu viruses are more common. “Making sure you cough or sneeze into your elbow and not on your hands will help cut down transmission of these viruses,” says Dr. Cutler. “And frequent, careful handwashing before you touch your own nose or mouth will help protect you from others who are sick.” Skipping handwashing is just one of the everyday mistakes that raise your risk of catching a cold, so protect yourself.
Watch out for norovirus
One of the most common viruses you’ll be exposed to is norovirus. “The norovirus has earned a reputation for being highly infectious, difficult to eliminate, and causing serious symptoms,” explains Dr. Cutler. Those symptoms include stomach pain, nausea, vomiting, and diarrhea. The virus can spread rapidly from person to person, he says: “Dormitories, cruise ships, hotels, and other public places are often the source of this virus.” Even if you’re vigilant with handwashing, others may not be. Spend a few extra seconds scrubbing your hands to avoid this bathroom mistake you didn’t know you were making.
Other types of germs
In addition to viruses, your hands can carry bacteria, fungi, and protozoa. Certain types of bacteria can cause infections like strep throat, explains Dr. Velikova. Unlike viruses, however, bacterial infections can be treated with antibiotics.
Fungi are another concern: “Although many fungi are harmless, if not beneficial, some of them can cause diseases such as thrush (Candida), Athlete’s foot, or ringworm,” says Dr. Velikova.
And then there are protozoa—parasites—that can carry serious diseases. “Protozoa are single-celled organisms that feed on microbes,” says Dr. Velikova. “They can cause malaria, toxoplasmosis, or giardiasis.” (Although malaria is spread by mosquitos in areas where it is endemic, not by touching surfaces.)
How these germs make us sick
When your body can’t fight off the germs you come into contact with, you get sick. “Infection is the first stage,” explains Dr. Velivkova. “It’s when your body has an immune response such as fever.” As the infection spreads, your body develops symptoms such as a cough or diarrhea.
Before you invest in a giant bubble to live in, remember that most germs you come into contact with on a daily basis won’t harm you. “Not every bacteria-infected surface will cause infection because our immune system is usually quite strong,” advises Dr. Velikova.
Also, keep in mind that while handwashing is always important, going overboard—having too sterile an environment for people who are otherwise healthy—is hypothesized to increase the risk of asthma and allergies in children.
How does handwashing prevent illness?
As you know, germs are everywhere: When you fail to wash your hands, you’re transmitting the bugs to your face where they can find entry to your body and begin to spread. According to the Centers for Disease Control and Prevention, most germs come into our bodies through our eyes, nose, and mouth because we frequently touch those areas of the body. Germs from our hands can also be passed onto food and drinks, making others sick. And these are 13 household items that can make you sick.
Washing your hands with soap and water or if those aren’t available, hand sanitizer, removes many of the germs that cause illness and cuts your risk for diarrhea, respiratory infections, and skin and eye infections.
Handwashing in the general population can reduce the risk of respiratory illnesses by 16 to 21 percent. Handwashing in schools can cut absenteeism due to diarrhea and other gastrointestinal problems by 29 to 57 percent, according to the Centers for Disease Control and Prevention.
You’re sick? Handwashing still helps
Even after you come down with an infection, washing your hands can help you not spread germs to other people. According to a 2015 study of 20,000 people in The Lancet, handwashing not only helped prevent illnesses, but it also halted their spread. Study participants who received handwashing training were less likely to contract a respiratory tract infection than a group that didn’t receive the education. But if the hand-washers did get sick, they were also less likely to spread their illness to family members.
So how often should you wash your hands?
You may be good about washing your hands after using the bathroom or changing a little one’s diaper, but it’s important to keep it up throughout the day—before meals, for example, and after getting off public transportation. Other important times to get to the sink include any time you’re preparing food, petting an animal, handling garbage, or caring for someone who is sick.
According to Dr. Cutler, prevention is key. “Wash your hands before you eat and any time you feel you may have come in contact with a surface which might spread its germs to you,” advises Dr. Cutler. “It’s also a good idea to carry a small bottle of hand sanitizer everywhere you go.”
Handwashing tips
Yes, you’ve been washing your hands on your own for decades—but most people are washing their hands wrong. Here’s a quick refresher from Dr. Cutler: When it’s time to wash, start by placing your hands under running water. Lather your hands with soap and start scrubbing. Be sure to clean between your fingers and under your nails. Aim to scrub for about 20 seconds or as long as it takes you to hum the Happy Birthday song twice. Rinse your hands under running water again and dry them with a clean, dry towel. Then go enjoy your day knowing that you’re much less likely to get sick.